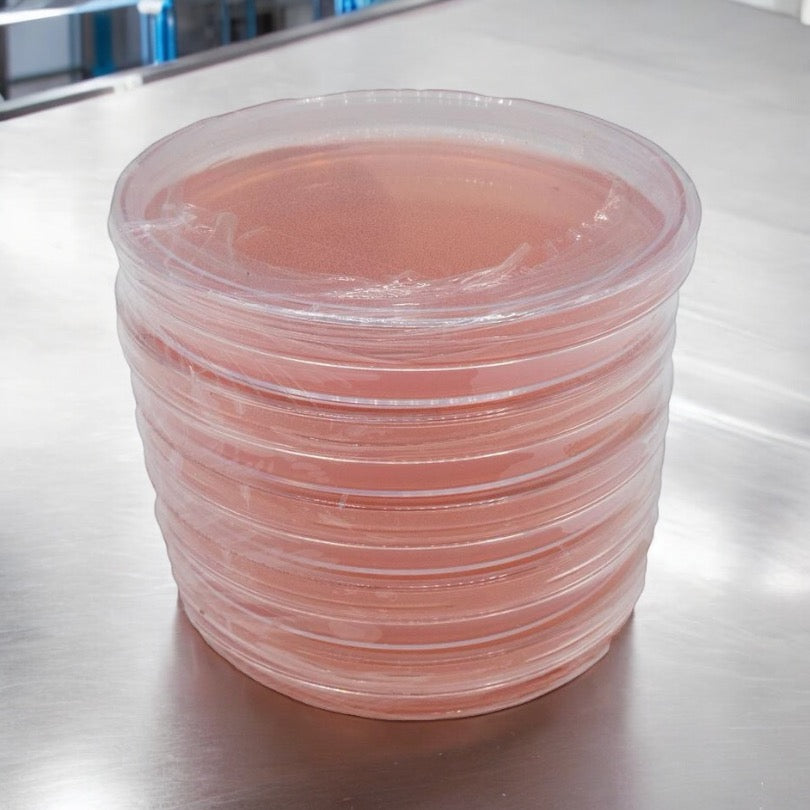

Premium Sterilized Malt Extract Agar Plates - 5 Pack
Microppose’s Premium Sterilized Malt Extract Agar Plates are expertly crafted to foster robust mycelium growth, making them an essential tool for mushroom cultivators. Here’s what sets them apart:
- Optimized for Growth: Formulated with a carefully selected blend of ingredients to create the perfect environment for mycelium development.
- Durable and Reliable: Constructed using 90mm polystyrene Petri dishes to ensure consistent quality and durability.
- Sterilized in a Controlled Environment: Each plate is pressure sterilized and poured in a clean-room environment, maintaining the highest standards of purity.
- Color-Coded for Convenience: Available in assorted colors to help track usage dates for best cultivation results.
- Freshly Made: Produced fresh daily and sealed in polyfilm to preserve quality.
Ingredients: Agar, Malt Extract, Yeast Extract, and Locust Gum.
Storage and Usage: For optimal performance, store the plates in the refrigerator and use them within 4 weeks of receipt.
What Are Agar Plates Used For?
Agar plates, particularly those made with Malt Extract Agar (MEA), are fundamental tools in microbiology and mycology for cultivating and isolating microorganisms like fungi. These plates provide a nutrient-rich, gelatinous surface ideal for supporting the growth of mycelium, the vegetative part of fungi.
In mushroom cultivation, agar plates are used to propagate and isolate fungal spores or tissue samples under sterile conditions. Spores or tissue are inoculated onto the agar surface, where mycelium grows and spreads when incubated at the correct temperature. These plates allow cultivators to monitor the health of the mycelium, ensuring it's free from contaminants before transferring it to a more substantial growing medium like grain or sawdust in a process called spawning.
Agar plates are a vital step in mushroom cultivation, ensuring the initial growth phase is strong and contaminant-free, which sets the foundation for healthy mushroom production.
Premium Sterilized Malt Extract Agar Plates - 5 Pack